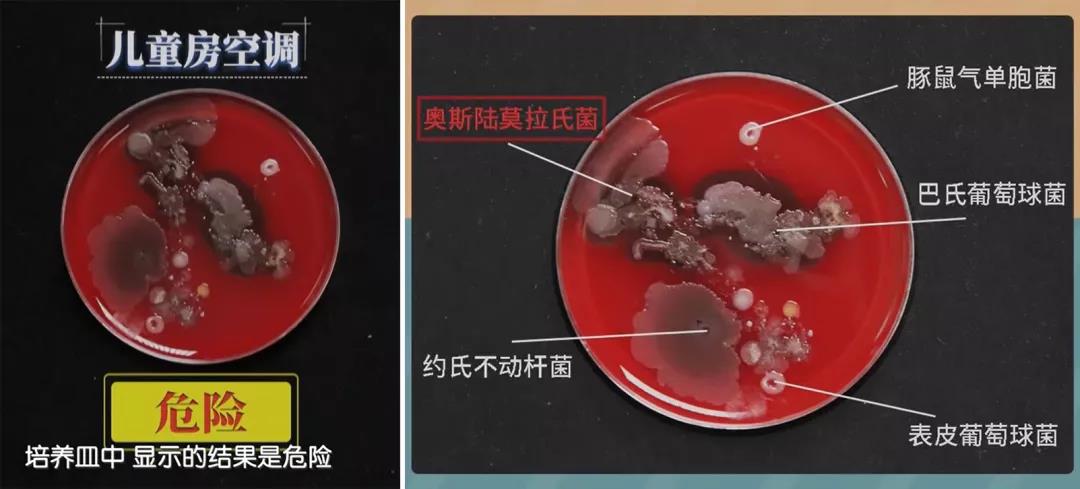
给娃这样开空调难怪会生病,孩子容易生病空调开什么模式好点

文丨京妈说,原创内容。
“不能开空调啊,容易得空调病,还容易感冒,热就给孩子少穿点,吹吹电风扇”。如果天热我们开空调时,可能经常被家里的老人这样劝阻。
这段时间越来越热了,同事小欢家的娃还不到一岁,加上娃本身就偏胖,背上、肚子上、脖子里起了很多痱子,娃经常因为热也因为痒而哭闹。
当每她想开空调时,娃奶奶就这样阻止,前几天因为痱子严重,带娃去看了医生,医生让开空调。

回来她和娃奶奶说明情况,就开了空调,等娃不哭闹,开心地玩起来时,奶奶就把空调给关了;过会儿娃又开始哭,奶奶就又开了一会儿,就这样开开关关的一天,结果第二天娃就感冒了。这下奶奶可有了说辞,觉得是开空调把娃给吹病了。
后来小欢自己琢磨娃为啥会感冒,才想起来可能是空调的风向不对,开着时是对着人直吹的,当时被娃奶奶搅的都忘记这事儿了,只想着能凉快一会儿是一会儿。

三不做:这样给娃开空调,难怪孩子会生病!
其实,吹空调本身没问题,容易生病,是因为没有“正确吹空调”,比如用这些方法给孩子吹空调,就更容易生病。
1、对着人直吹
也就是前面同事小欢家的情况,空调的遥控器上 有调节风向的按钮,不仅是孩子,大人也不宜直吹,容易头疼感冒。
除了改变风向,也可以装个空调挡板,十几二十块钱,不贵还方便,对孩子的健康也是多了一重防护。

2、温度开的太低
很多人喜欢把空调开的很低,让室内特别凉,尤其晚上睡觉,甚至有人开到16°,盖着被子睡觉。
这样的方法,对于有小宝宝的家庭来说,并不合适。
空调温度过低,会导致室内温差过大,尤其是带宝宝出去玩,频繁的进出空调房,如果两个环境的温差过大,就容易让娃生病。
一般有孩子的家庭,开空调时让室温处于24-26℃,最好不低于24℃。
而且如果是 从空调房带娃出去玩,外面温度高,可以这样做:先把空调关了,开窗给室内通风换气,让室内温度逐渐上来,待十来分钟再出去。

3、从来不清洗空调
每年在开始使用空调时,要先把过滤网清洗下,一个夏天用下来,很容易积粉尘,如下图是 用了一个夏天的空调过滤网,有多脏一眼就看的清楚。

央视科技频道《健康频道》联合中国疾控中心给嘉宾做过 空调细菌检测,其中一位嘉宾是妈妈,检测的是 儿童房的空调,从外面看挺干净的空调,但里面还是有不少积灰。

来源于@教科频道《健康之路》栏目
疾控中心给出的检测结果是:危险。
因为空调中藏着 容易引起呼吸道感染的致病菌:奥斯陆莫拉菌、约氏不动杆菌,尤其给孩子使用,更是要警惕。
来源于@教科频道《健康之路》栏目
四合适:开空调把握好几个关键点,孩子才不容易感冒生病
夏天本来就热,不开空调不是明智之举,开空调不想让孩子生病,除了温度合适、不对着孩子直吹外,还得把握好这几个关键点。
1、空调房内穿衣合适
打开空调后,室内温度会马上降下来,让人感觉凉爽,这时候就最好给孩子换上合适的衣服了,比如穿个长袖的衣裤、小袜子,尤其注意保护好小肚子。

2、通风合适
开空调,除了过滤网的细菌容易让孩子生病外,还有个需要注意的方面,那就是避免24小时开空调,不通风换气。
可以白天最热的时候开几个小时,早晚凉快了就关掉空调,开窗通风,这样才能确保室内空气新鲜,避免出现身体不适。
3、湿度合适
在北方比较干燥,使用空调时也要同时注意加湿;而在南方多雨潮湿,使用空调时,可以适当使用除湿功能,毕竟湿度高更容易滋生细菌。
可以买个温度湿度计挂在家里,勤观察,保持湿度在50%-60%,若是不在这个范围之内,家长要及时做出调整。

4、使用方法合适
除了前面说到的定期清洗,温度和风向合适外,还要 避免让孩子频繁的进出空调房,不然忽冷忽热的温度刺激,对于体温调控能力尚未发育完善的孩子来说,就很容易生病。
比如从外面玩回来,先让孩子坐下来喝点水,歇会儿,没那么多汗了再空调;如果是准备出去玩,先把空调关了,在家待会再出去。

总之,到了夏天天气热的时候,一定要开空调,别盲目的让宝宝热着,容易长痱子,也容易中暑,只是注意开空调的方法正确就好,这样宝宝舒服了,减少生病,对于生长发育也好。
你家到了夏天会吹空调吗,当给娃吹空调时,家里的老人会反对不?来说说你家的育儿经呀。
关注「京妈说」,学习更多专业实用又接地气的母婴育儿知识,如果你喜欢这篇文章,要给京妈点赞并分享给更多的人哦。